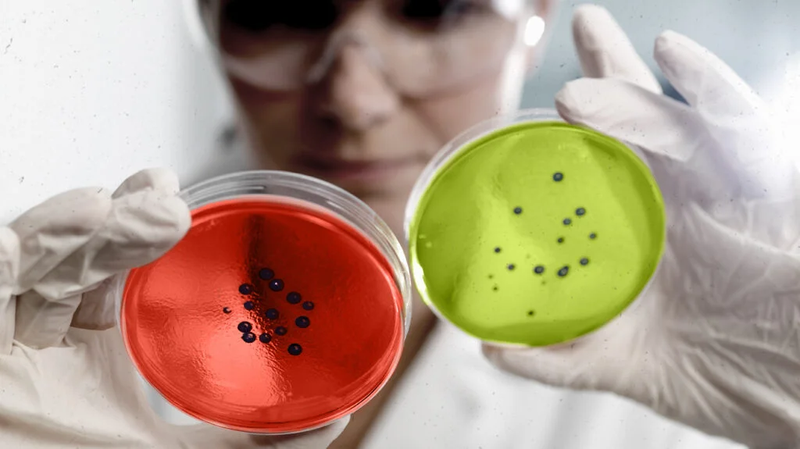
Nhuộm gram là gì? Quy trình thực hiện và cách phân tích kết quả 2

Quy trình nhuộm gram được xem là bước đầu tiên để có thông tin về loại vi khuẩn gây ra căn bệnh đó, sau đó các bác sĩ sẽ tiến hành nuôi cấy và định danh vi khuẩn để phân biệt cấu trúc và tính chất của vi khuẩn nhanh chóng và có cách điều trị hiệu quả các bệnh do nhóm vi khuẩn gây ra. Bài viết dưới đây sẽ cung cấp đến bạn đọc một số thông tin về thuật ngữ chuyên khoa này, mọi người cùng theo dõi nhé.
Kỹ thuật nhuộm gram là gì?
Nhuộm gram là phương pháp xác định loại vi khuẩn nhanh, được phát minh từ năm 1884 bởi nhà khoa học tên Gram. Cho đến ngày nay vẫn được ứng dụng trong chẩn đoán vi sinh học để nhận biết sớm các bệnh nhiễm khuẩn do loại vi khuẩn nào gây ra và xác định hướng điều trị phù hợp với bệnh nhân.
Kỹ thuật nhuộm gram được thực hiện dựa trên đặc tính lý hóa của thành tế bào (được lấy trên cả dịch cơ thể hoặc mẫu sinh thiết nghi ngờ nhiễm khuẩn), sau đó sẽ chia vi khuẩn thành 2 loại chính: Vi khuẩn gram âm (-) và vi khuẩn gram dương (+).
Các loại thuốc cần sử dụng để thực hiện nhuộm gram bao gồm: Dung dịch tím gentian, dung dịch lugol, tẩy cồn acetone và dung dịch đỏ fuchsin.
 Phương pháp nhuộm gram dùng để xác định nhóm vi khuẩn gây bệnh dựa vào mẫu sinh thiết hoặc dịch cơ thể
Phương pháp nhuộm gram dùng để xác định nhóm vi khuẩn gây bệnh dựa vào mẫu sinh thiết hoặc dịch cơ thểNguyên lý thực hiện kỹ thuật nhuộm gram
Lớp vách tế bào của 2 loại vi khuẩn sẽ quyết định đến tính chất bắt màu trong quá trình nhuộm, trong đó màu sắc của hai loại vi khuẩn này như sau:
- Vi khuẩn gram dương: Màu tím.
- Vi khuẩn gram âm: Màu hồng.
Bên cạnh cấu trúc tế bào, mỗi loại sẽ có các đặc điểm riêng như sau.
Đặc điểm vi khuẩn gram dương
Vi khuẩn gram (+) có vách tế bào peptidoglycan dày, dạng lưới có độ bắt màu nhạy với thuốc nhuộm tím gentian tinh thể, tuy nhiên quá trình tẩy cồn sẽ khó hơn vi khuẩn gram (-) hơn. Những vi khuẩn này sẽ được phân loại là vi khuẩn gram dương như: Tụ cầu khuẩn, phế cầu khuẩn s.pneumoniae,…
Xác định vi khuẩn gram dương và gram âm dựa trên màu sắc của vách tế bào sau khi nhuộm gram
Xác định vi khuẩn gram dương và gram âm dựa trên màu sắc của vách tế bào sau khi nhuộm gramĐặc điểm vi khuẩn gram âm
Ngược lại với vi khuẩn gram (+), lớp vách của vi khuẩn gram (-) sẽ dày hơn và có thêm lớp lipopolysaccharide bên ngoài. Do đó ở bước tẩy cồn có thể hòa tan được lớp màng, nên nó không giữ được màu tím của thuốc nhuộm mà sẽ bắt màu thuốc nhuộm dung dịch fushin kiềm, có màu đỏ hoặc hồng.
Các vi khuẩn bắt màu gram âm phổ biến như: Vi khuẩn gây bệnh thương hàn, E. coli, lậu cầu, não mô cầu,…
5 bước trong quy trình nhuộm gram
Quy trình nhuộm gram sẽ gồm các bước sau đây, trong đó bước tẩy màu giữ vai trò quan trọng có sự ảnh hưởng đến kết quả.
Bước 1: Dàn đều dịch cơ thể hoặc mẫu sinh thiết nghi ngờ nhiễm khuẩn lên lam kính sạch.
Bước 2: Cố định mẫu bệnh phẩm bằng cách hơ trên ngọn lửa đèn cồn và để nguội.
Bước 3: Thực hiện 4 bước nhuộm quan trọng:
- Đầu tiên cần nhuộm tất cả vi khuẩn thành màu tím, bằng cách phủ dung dịch tím gentian và để khoảng 30 giây sau đó rửa dưới vòi nước chảy nhẹ.
- Tiếp theo cần phân loại vi khuẩn đậm hay nhạt bằng cách phủ dung dịch lugol để cố định màu, để nguyên trong 30 giây rồi rửa dưới vòi nước.
- Bước quan trọng nhất tẩy màu tẩy màu bằng cồn acetone để trong 30 giây và rửa lại dưới nước, để phân biệt loại vi khuẩn nào chắc màu và loại nào bị tẩy trôi sau khi phủ qua dung dịch lugol.
- Cuối cùng là bước phủ dung dịch đỏ fuchsin để khoảng 30 giây rồi rửa dưới nước, để xác định các vi khuẩn nào được tẩy hết màu tím bắt lại màu đỏ, trong đó các vi khuẩn chắc màu tím sẽ không bị đổi màu.
Bước 4: Để khô tự nhiên.
Bước 5: Soi dưới vật kính dầu.
Sau khi hiểu được đặc điểm của từng loại vi khuẩn sau khi thực hiện quy trình nhuộm gram, mọi người cũng biết được vì sao bước tẩy màu mang ý nghĩa cực kỳ quan trọng và người thực hiện cần phải có kỹ năng nhất định vì khả năng bắt màu của vi khuẩn gram dương có tỷ lệ chưa cao nên rất dễ đưa ra kết luận sai.
 Quy trình thực hiện nhuộm gram cần có 5 bước
Quy trình thực hiện nhuộm gram cần có 5 bướcCách phân tích kết quả để phân biệt vi khuẩn gram âm và gram dương
Từ kết quả đã thu được trong quy trình nhuộm gram, bác sĩ có thể dựa vào sự biến đổi màu sắc để phân biệt vi khuẩn thành hai nhóm chính vi khuẩn gram âm và vi khuẩn gram dương.
Cụ thể sẽ có 3 cách để phân biệt vi khuẩn như sau:
Xem kết quả sau khi nhuộm gram
Vi khuẩn gram dương: Vi khuẩn gram dương sẽ có màu tím hoặc màu xanh tím, vì vách tế bào của chúng chứa nhiều peptidoglycan và không có màng ngoại, do đó chất nhuộm dễ xuyên qua và bám vào tế bào vi khuẩn chuyển thành màu tím.
Vi khuẩn gram âm: Vi khuẩn gram âm không bắt màu sau quá trình nhuộm, thường là màu xanh lam hoặc xanh lá cây, vì vách tế bào của vi khuẩn gram âm ít peptidoglycan hơn và có màng ngoại nên sẽ khó bắt màu.
Phân biệt các vi khuẩn
Vi khuẩn gram dương: Có thể xác định nhanh chóng qua màu sắc sau khi nhuộm gram và giúp nhận biết bệnh viêm họng do liên cầu khuẩn, vi khuẩn tụ cầu staphylococcus và vi khuẩn enterococcus.Vi khuẩn gram âm: Khi vi khuẩn không bắt màu, bác sĩ có thể kết luận nhanh rằng chúng thuộc nhóm gram âm, bao gồm một số loại phổ biến như escherichia coli, salmonella, pseudomonas và neisseria.
 Xác định vi khuẩn có thể dựa vào kết quả, màu sắc và tính sinh học
Xác định vi khuẩn có thể dựa vào kết quả, màu sắc và tính sinh họcTính chất sinh học của từng vi khuẩn
Vi khuẩn gram dương: Sẽ có lớp peptidoglycan dày, ít acid teichoic và có khả năng tạo thành nhiều enzyme, chất độc, vác tử cung và lớp màng men màng hãm.Vi khuẩn gram âm: Ngược lại có lớp peptidoglycan mỏng, nhiều acid teichoic và có màng ngoại chứa lipopolysaccharide (LPS) và protein. Có khả năng kháng lại một vài kháng sinh.
Lưu ý 4 nguyên nhân ảnh hưởng đến kết quả nhuộm gram
Kỹ thuật nhuộm gram đối với người thường xuyên thực hiện có thể đơn giản nhưng vẫn không tránh khỏi một số sai lệch khi đưa ra kết quả, trong đó có thể xuất phát từ các nguyên nhân sau:
- Thời gian tẩy cồn không đảm bảo thời gian, có thể quá dài hoặc quá ngắn không thể đưa ra kết quả chính xác.
- Thuốc nhuộm không đảm bảo chất lượng do nhiều yếu tố khách quan như để quá lâu trước khi sử dụng hoặc có nhiều cặn.
- Dàn tiêu bản quá dày hoặc quá mỏng.
- Cố định tiêu bản không kỹ trong quá trình rửa bị bong tiêu bản.
Việc tìm đúng loại vi khuẩn gây bệnh là điều rất quan trọng ảnh hưởng đến phác đồ điều trị về sau. Do đó mọi người nên tìm hiểu kỹ và lựa chọn các bệnh viện lớn có nhiều năm kinh nghiệm để thực hiện khám chữa bệnh và chăm sóc sức khỏe, hạn chế trường hợp kết luận sai và mất nhiều thời gian, chi phí mà không đúng bệnh.
Bài viết trên đã cung cấp các thông tin về các bước thực hiện quy trình nhuộm gram, cách dựa vào tính chất màu sắc và sinh học từ kết quả để phân biệt nhóm vi khuẩn, từ đó các bác sĩ sẽ đưa ra chẩn đoán chính xác hơn và có hướng điều trị phù hợp cho mỗi bệnh nhân.
Xem thêm:
Vi khuẩn nhuộm soi và những điều cần biết
Xét nghiệm vi khuẩn nhuộm soi là gì – Bạn đã biết chưa?
